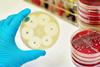
Image

All Sequencing articles – Page 5
-
 Webinar
WebinarBridging the gap: using organ-on-a-chip as an experimental tool to develop (cost) effective therapeutics
The webinar will explore primary concerns in drug discovery development and why drugs fail.
-
 News
NewsGut bacteria linked to fatty deposits in heart arteries
Swedish study reveals a significant link between specific gut bacteria and the development of coronary atherosclerotic plaques, a leading cause of heart attacks.
-
 Whitepaper
Whitepaperebook: Fluorescence polarization assays
This ebook outlines the basics of fluorescence polarization and discusses the advantages and limitations of FP-based biochemical assays.
-
 News
NewsDNA technology helps slow down and scan molecules multiple times
Swiss researchers have achieved near-perfect control over the manipulation of individual DNA molecules, allowing them to be identified and characterised with unprecedented precision
-
 News
NewsGenomic sequencing helps find treatment for rare genetic skin disorder
US researchers use genome sequencing to reveal genetic basis for disabling pansclerotic morphea, a severe inflammatory disease.
-
 News
NewsDiverse senescent cell populations uncovered by single-cell RNA sequencing
Single-cell transcriptomic RNA sequencing analysis has allowed US researchers to identify the specific populations and the dynamic transition states during senescence initiation and progression.
-
 News
NewsNovel tool helps differentiate between cancerous and healthy cells for AML
Spanish scientists have developed a new method to identify between cancerous and healthy cells for cases of acute myeloid leukaemia (AML).
-
News
NewsAntimicrobial resistance identified in bloodstream by metagenomic sequencing
University of Oxford finds rapid metagenomics can produce accurate results 18-42 hours quicker than conventional tests for antimicrobial resistance in bloodstream infections, which could save lives and reduce the misuse of antibiotics.
-
 Whitepaper
WhitepaperApplication note: Single Cell Deposition Efficiency
Comparison of single cell dispensing efficiency between Namocell Single Cell Dispenser and limiting dilution method.
-
 Whitepaper
WhitepaperGuide: Tips for Single Cell Isolation
Single cell isolation is a critical step for a number of workflows, and can greatly impact the success of downstream applications.
-
 News
NewsNew self-powered drug delivery system
US researchers have invented a drug delivery technology that has implications for opioid epidemic, cancer treatment, rehabilitation care and more.
-
 Whitepaper
WhitepaperApplication note: Generating clonal GFP cell lines
Namocell single cell dispensers use gentle sorting pressure to isolate and dispense GFP-positive cells into 96-well plates.
-
 Whitepaper
WhitepaperApplication note: Enrichment of high titer CHO clones
A selective FACS-enrichment was performed via the enrichment mode of Namocell Single Cell Dispenser to enrich for high titer CHO cells.
-
 News
NewsResearchers develop novel method to insert large DNA sequences more accurately in cells
The scientists say that the engineered CRISPR enzymes could overcome key limitations for eventual use to treat genetic diseases irrespective of a patient’s particular mutation.
-
 News
NewsStudy identifies gene and proteins that could treat dry eye disease
Researchers found that proteins made by stem cells that regenerate the cornea could be new targets for treating dry eye disease.
-
 News
NewsStudy suggests existing cancer drug may be effective against non-alcoholic fatty liver disease
The researchers used single-nuclear sequencing and advanced three-dimensional glass imaging of mice to find new drug targets for non-alcoholic fatty liver disease.
-
 News
NewsStem cell model shows early stages of differences in sex development in mice and humans
Israeli researchers develop new model that will help pinpoint complications in individuals with Differences in sex development (DSD).
-
 News
NewsScientists identify a biomarker that predicts CAR T-cell therapy efficacy
Combining AI with cutting-edge flow cytometry and massive sequencing technologies, researchers describe CAR T cell characteristics that determine their therapeutic capacity for the first time.
- Previous Page
- Page1
- Page2
- Page3
- Page4
- Page5
- Next Page



